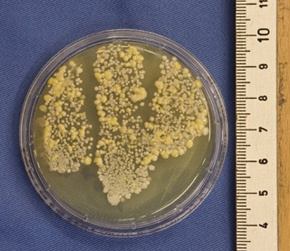
Abb. 1 : Abklatschpräparat vor hygienischer Händedesinfektion (Foto: dvta).

Hygiene im Krankenhaus lässt sich nicht verordnen

Die Hygiene in Krankenhäusern lässt sich nicht über neue Verordnungen verbessern. Der Deutsche Verband Technischer Assistentinnen und Assistenten in der Medizin e.V. erwartet durch das geplante Krankenhaushygienegesetz keinen Rückgang der im Krankenhaus erworbenen Infektionen. Vielmehr sei jeder Einzelne gefragt.
Die Wahrscheinlichkeit, sich in deutschen Krankenhäusern mit einem gegen Antibiotika resistenten Erreger zu infizieren, ist höher als beispielsweise in den skandinavischen Ländern oder den Niederlanden. Das von der Bundesregierung noch für dieses Jahr angekündigte Krankenhaushygienegesetz soll Abhilfe schaffen.
„Das wirksame Mittel gegen im Krankenhaus erworbene Infektionen heißt Hygiene und die lässt sich nicht verordnen", so Andrea Michelsen, Vorstandsvorsitzende des Deutschen Verbandes Technischer Assistentinnen/Assistenten in der Medizin e.V. (dvta). „Neben dem Infektionsschutzgesetz existieren sehr gute Empfehlungen des Robert-Koch-Institutes zur Krankenhaushygiene. Die müssen endlich konsequent umgesetzt und von Fachkräften kontrolliert werden", so Michelsen weiter. Hygiene bedarf laut der Vorstandsvorsitzenden keiner neuen Gesetzgebung, sondern vielmehr der Selbstdisziplin und der regelmäßigen Schulung. Medizinisch-technische Assistentinnen für Laboratoriumsmedizin leisten hier bereits einen wirksamen Beitrag.
„Zur Überwachung erstellen wir Präparate von z.B. Waschmaschinen für Endoskope, Luftfiltern, Türklinken oder Wischproben aus Kühlschränken. Oder wie hier zu sehen Präparate von Händen vor und nach hygienischer Händedesinfektion zu Schulungszwecken. Auch nach der hygienischen Händedesinfektion lässt sich noch Keimwachstum nachweisen.", erläutert Michelsen die Präparate. Eine hygienische Händedesinfektion sollte 30 Sekunden dauern. Für die chirurgische Händedesinfektion sind 3-5 Minuten Einwirkzeit vorgeschrieben.
„Solange Vorgesetzte ihre Vorbildfunktion nicht wahrnehmen, selber keine sterilen Handschuhe oder Schutzkleidung tragen und so die Grundregeln der Hygiene nicht beachten, brauchen wir uns nicht wundern, wenn die Infektionsraten hoch sind. Darauf muss jeder einzelne Mitarbeiter mit Patientenkontakt achten", fordert Michelsen für die Praxis.
Als nosokomiale Infektionen definiert das Robert-Koch-Institut Infektionen, die während des Krankenhausaufenthaltes erworben worden sind. Eine spezielle Gruppe der im Krankenhaus erworbenen Infektionen sind die multiresistenten Erreger. Bei dieser Gruppe wirken nur noch wenige oder gar keine Antibiotika mehr. Infektionen mit multiresistenten Erregern können besonders bei Menschen mit schwachem Immunsystem oder bei älteren Menschen schwere Infektionen hervorrufen. Im Jahr 2009 starben rund 15.500 Menschen an infektiösen oder parasitären Krankheiten. Damit machen die Infektionskrankheiten 1,8 % der Todesursachen aus. Das geplante Krankenhaushygienegesetz verpflichtet die Bundeländer unter anderem zum Erlass von Hygieneverordnungen. Bisher ist dies den Ländern selbst überlassen. Das Krankenhausbarometer des Deutschen Krankenhausinstituts weist bei den in Krankenhäusern getroffenen Maßnahmen zur Verhinderung nosokomialer Infektionen allerdings keinen nennenswerten Unterschied zwischen Ländern mit und ohne Hygieneverordnung nach.
Anbieter
dvta Deutsche Verband Technischer Assistentinnen und Assistenten in der Medizin e.VSpaldingstr. 110 b
20097 Hamburg
Deutschland
Meist gelesen

Prof. Dr. Julia Heinzelbecker übernimmt die Direktion der Klinik für Urologie am Universitätsklinikum Marburg
Das Universitätsklinikum Marburg freut sich, Prof. Dr. Julia Heinzelbecker als neue Direktorin der Klinik für Urologie begrüßen zu dürfen. Mit ihrer großen Erfahrung in der Patientenversorgung, Forschung und Lehre wird sie das Fachgebiet in Marburg weiter ausbauen und modern gestalten.

Universitätsklinikum Marburg: Prof. Dr. Dr. Rainer Lutz übernimmt die Direktion
Seit dem 1. Oktober 2025 steht die Klinik und Poliklinik für Mund-, Kiefer- und plastische Gesichtschirurgie (MKG) am Universitätsklinikum Marburg unter neuer Leitung. Prof. Dr. Dr. Rainer Matthias Lutz, FEBOMFS, hat die Nachfolge von Prof. Dr. Dr. Andreas Neff angetreten.

Prof. Dr. iur. Christian Höftberger ist neues KfH-Vorstandsmitglied
Das Präsidium des gemeinnützigen KfH Kuratorium für Dialyse und Nierentransplantation e.V. hat Prof. Dr. iur. Christian Höftberger mit Wirkung zum 1. Oktober 2025 in den Vorstand berufen. Zum 1. April 2026 wird er die Position des Vorstandsvorsitzenden von Prof. Dr. med. Dieter Bach übernehmen, der nach 13 Jahren in den Ruhestand tritt und sich neuen Aufgaben widmen wird.

Management & Krankenhaus Mediadaten 2026
Die Mediadaten liefern Ihnen umfassende Informationen zu Auflage & Verbreitung, der Leserschaft, Themenplänen & redaktionellen Schwerpunkten.

Gemeinschaftsklinikum Mittelrhein: Prof. Dr. Karsten Wrede ist neuer Chefarzt
Die Neurochirurgie an den Koblenzer Standorten erhält eine neue Führung









